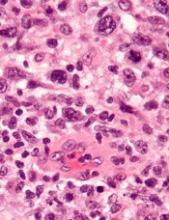

Preclinical research indicates that TYK2 inhibitors could be effective in treating anaplastic large-cell lymphoma (ALCL).
Researchers found evidence to suggest that TYK2 “is highly expressed in all cases of human ALCL.”
The team also discovered that TYK2 inhibition induces apoptosis in ALCL cells, and it delays tumor onset and prolongs survival in a mouse model of ALCL.
Olaf Merkel, PhD, of the Medical University of Vienna in Austria, and his colleagues detailed these findings in Leukemia.
The researchers said their analyses suggest TYK2 is expressed in all types of ALCL, regardless of ALK status, and TYK2 mediates the same anti-apoptotic response across ALCLs.
“Therefore, we could consider TYK2 signaling as the Achilles’ heel of ALCL, as, in all patients we have analyzed, the tumor cells relied on this activity to support the essential survival signal,” Dr. Merkel said.
He and his colleagues found that disrupting TYK2—either via gene knockdown or with small-molecule TYK2 inhibitors—induced apoptosis in human ALCL cells in vitro.
In a mouse model of NPM-ALK-induced lymphoma, Tyk2 deletion slowed the rate of tumor growth and significantly prolonged survival. The median survival was 53.3 weeks in mice with Tyk2 deletion and 16.0 weeks in control mice (P<0.0001).
Additional experiments in human ALCL cell lines showed that “TYK2 is activated by autocrine production of IL-10 and IL-22 and by interaction with specific receptors expressed by the cells,” the researchers said.
They also found that “activated TYK2 leads to STAT1 and STAT3 phosphorylation, activated expression of MCL1, and aberrant ALCL cell survival.”
Taking these findings together, the researchers concluded that TYK2 inhibitors could be effective for treating ALCL.
“We are looking forward to TYK2 inhibitors becoming available . . . ,” said study author Lukas Kenner, MD, of the Medical University of Vienna.
“[I]n the more rare lymphomas, we urgently need better therapies.”